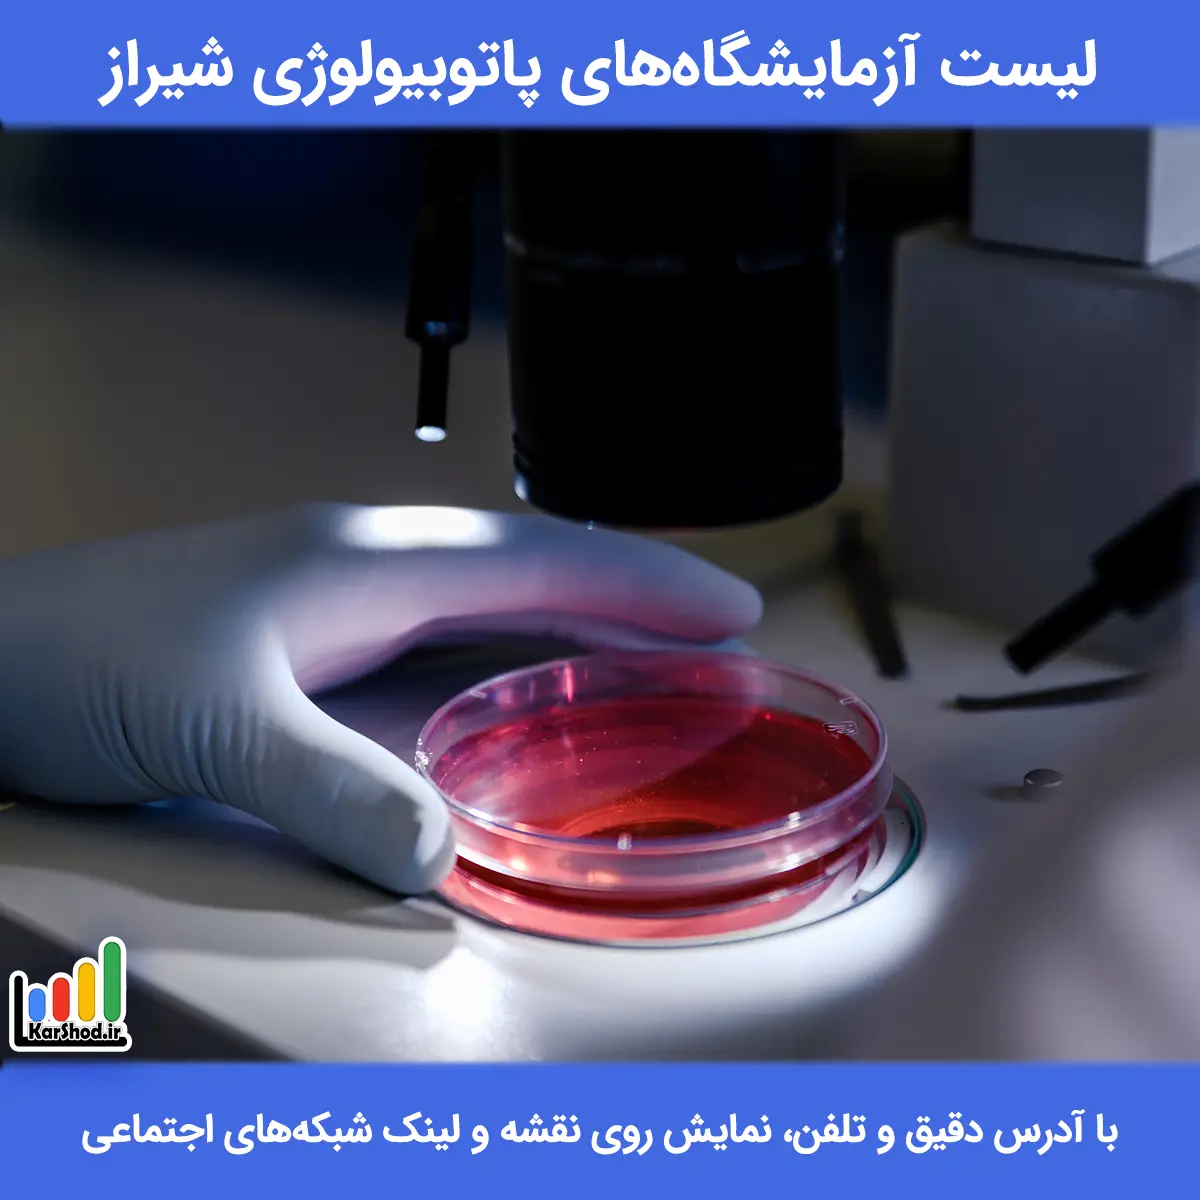

لیست کامل بهترین آزمایشگاه های پاتوبیولوژی شیراز 1404 | آدرس و تلفن
آزمایشگاه پاتوبیولوژی در شیراز یکی از مهمترین مراکز تشخیصی پزشکی است. تشخیص دقیق بیماری ها بدون بررسی تخصصی نمونه های بافتی و سلولی ممکن نیست. به همین دلیل انتخاب آزمایشگاه مناسب، نقش مستقیمی در مسیر درمان دارد. کاربران هنگام انتخاب آزمایشگاه به دقت تشخیص، تجربه پزشک و سرعت پاسخ دهی توجه ویژه ای دارند.
در شهر شیراز آزمایشگاه های متعددی در این حوزه فعالیت میکنند. اما کیفیت خدمات آنها یکسان نیست. تفاوت در تجهیزات، تخصص و نحوه گزارش دهی باعث شده بسیاری از افراد به دنبال بهترین آزمایشگاه پاتوبیولوژی در شیراز باشند.
وبسایت کارشد؛ بانک مشاغل شیراز، در پاییز 1404 جاری اطلاعات آزمایشگاه های پاتوبیولوژی شیراز را گردآوری کرده است. هدف این صفحه، کمک به انتخابی آگاهانه و مطمئن است.
لیست آزمایشگاه های پاتوبیولوژی شیراز + آدرس و تلفن
اطلاعات این صفحه و لیست آزمایشگاه های پاتوبیولوژی شیراز با دقت و از منابع معتبر گردآوری شدهاند. با این حال، ارزیابی نهایی خدمات بر عهده شماست. پیشنهاد میکنیم پیش از انتخاب، بررسیهای لازم را انجام دهید.
آزمایشگاه پاتوبیولوژی گیتی
اکنون بسته است
آزمایشگاه پاتوبیولوژی گیتی، به مدیریت دکتر راحیل گیتی، در معالیآباد شیراز با تجهیزات پیشرفته و پرسنل مجرب، کلیه آزمایشات تشخیص طبی و پاتولوژی را ارائه میدهد. خدمات شامل خونشناسی، میکروبشناسی، غربالگری جنین، آییوآی و نمونهگیری در منزل است. این آزمایشگاه با بیمههای پایه و تکمیلی متعددی قرارداد دارد و به دلیل جوابدهی سریع، خونگیری تخصصی کودکان و خدمات دقیق، یکی از بهترین مراکز آزمایشگاهی شیراز محسوب میشود.
- آدرس: شیراز - معالی آباد، نبش خيابان پزشكان، مجتمع پزشكان، طبقه چهارم، واحد ٤١
- نمایش لوکیشن روی نقشه
- شماره موبایل: 0937 236 4511
- ساعت کاری امروز چهارشنبه: 7 تا 21:30
- آدرس اینستاگرام: giti_laboratory
- واتس اپ: ارسال پیام
- 🔗 مشاهده پروفایل اختصاصی
آزمایشگاه دکتر ثبات
- آدرس: شیراز - کلبه سعدی، بلوار بوستان سعدی، روبروی آرامگاه سعدی، جنب مسجد جامع
- نمایش لوکیشن روی نقشه
- شماره تماس: 07137331078 09018063386
- 🔗 مشاهده پروفایل
آزمایشگاه پاتوبیولوژی هرمس
- آدرس: شیراز - قدوسی غربی، بین کوچه 16 و 18، ساختمان هرمس، طبقه زیرزمین
- نمایش لوکیشن روی نقشه
- شماره تماس: 07191098656 09179001828
- آدرس اینستاگرام: hermes_laboratory
- 🔗 مشاهده پروفایل
آزمایشگاه دکتر صالحی
- آدرس: شیراز - بلوار کریم خان زند، كوچه 47، پلاك 14
- نمایش لوکیشن روی نقشه
- شماره تماس: 07132352223
- آدرس اینستاگرام: drsalehilab.shiraz
- 🔗 مشاهده پروفایل
آزمایشگاه پاتوبیولوژی اکسیر
- آدرس: شیراز - پل زرگری به سمت خبرنگار، ساختمان ابن سینا، طبقه 4، واحد 15
- نمایش لوکیشن روی نقشه
- شماره تماس: 07136275746 09170363755
- آدرس اینستاگرام: laboratoryexir
- 🔗 مشاهده پروفایل
آزمایشگاه مهر آگین
- آدرس: شیراز - خیابان فلسطین(باغشاه)، تقاطع معدل، ساختمان مهسا، طبقه اول
- نمایش لوکیشن روی نقشه
- شماره تماس: 07132369464 09177075662
- آدرس اینستاگرام: mehragin_lab
- 🔗 مشاهده پروفایل
آزمایشگاه پاتوبیولوژی کوثر
- آدرس: شیراز - معالی آباد، روبروی پارک ملت، ساختمان طوبی 8
- نمایش لوکیشن روی نقشه
- شماره تماس: 07136258680 09178134767
- 🔗 مشاهده پروفایل
آزمایشگاه راز
- آدرس: شیراز - خیابان معدل، حدفاصل باغشاه و ملاصدرا
- نمایش لوکیشن روی نقشه
- شماره تماس: 07132369393 09305489770
- آدرس اینستاگرام: razlab.ir
- 🔗 مشاهده پروفایل
آزمایشگاه پاتوبیولوژی رایان
- آدرس: شیراز - خیابان معدل غربی(حدفاصل فلسطین و هفت تیر)، بر روی خیابان پلاک 180
- نمایش لوکیشن روی نقشه
- شماره تماس: 07191009897 09170201313
- آدرس اینستاگرام: rayan.laboratory
- 🔗 مشاهده پروفایل
آزمایشگاه پاتوبیولوژی و ژنتیک اکسیژن
- آدرس: شیراز - بلوار کریم خان زند، خیابان 7 تیر(20متری سینما سعدی)، کوچه 10، ساختمان آزمایشگاه اکسیژن
- نمایش لوکیشن روی نقشه
- شماره تماس: 09308618744
- آدرس اینستاگرام: oxygenlab.ir
- 🔗 مشاهده پروفایل
آزمایشگاه پاتوبیولوژی پیوند
- آدرس: شیراز - ملاصدرا، خیابان اردیبهشت، حدفاصل 20 متری و صورتگر، نبش کوچه 2
- نمایش لوکیشن روی نقشه
- شماره تماس: 07132318700 09052411827
- آدرس اینستاگرام: peyvandlabcomplex_shiraz
- 🔗 مشاهده پروفایل
آزمایشگاه پاتوبیولوژی بزرگمهر
- آدرس: شیراز - خیابان قصردشت، بین کوچه 45 و 47، ساختمان بزرگمهر
- نمایش لوکیشن روی نقشه
- شماره تماس: 07136276230
- آدرس اینستاگرام: bozorgmehrlab
- 🔗 مشاهده پروفایل
آزمایشگاه دکتر نشاط
- آدرس: شیراز - بلوار کریم خان زند، بالاتر از بیمارستان شهید فقیهی، ابتدای کوچه عبائیان، طبقه فوقانی بانک سینا
- نمایش لوکیشن روی نقشه
- شماره تماس: 07132335763
- آدرس اینستاگرام: neshatlabcomplex
- 🔗 مشاهده پروفایل
آزمایشگاه پاتوبیولوژی مهرگان
- آدرس: شیراز - خیابان هفت تیر، نبش چهارراه معدل، طبقه فوقانی داروخانه دکتر ابطحیان
- نمایش لوکیشن روی نقشه
- شماره تماس: 07132358144 09385419822
- 🔗 مشاهده پروفایل
آزمایشگاه پاتوبیولوژی دکتر فرهمند
- آدرس: شیراز - قصردشت، بین کوچه 53 و 55، رو به روی خشکبار تفرشی
- نمایش لوکیشن روی نقشه
- شماره تماس: 07136263962 09053281117
- 🔗 مشاهده پروفایل
آزمایشگاه دکتر رحمان نیا
- آدرس: شیراز - ابتدای 20 متری سینما سعدی از سمت زند، نرسیده به چهارراه اردیبهشت
- نمایش لوکیشن روی نقشه
- شماره تماس: 07132317965 09392011757
- آدرس اینستاگرام: rahmannia.lab
- 🔗 مشاهده پروفایل
آزمایشگاه پاتوبیولوژی اهورا
- آدرس: شیراز - معالی آباد، بین خیابان دوستان و خلبانان، نبش کوچه 23، مجتمع اهورا، طبقه 4، واحد 46
- نمایش لوکیشن روی نقشه
- شماره تماس: 07136341417 09395270853
- آدرس اینستاگرام: ahoora_lab
- 🔗 مشاهده پروفایل
آزمایشگاه دکتر جان نثار
- آدرس: شیراز - بلوار پاسداران، نبش کوچه ۶۶(روبروی خیابان جهان آرا)، ساختمان الینا، طبقه سوم
- نمایش لوکیشن روی نقشه
- شماره تماس: 07138329112 09397059398
- آدرس اینستاگرام: dr_jannesar_laboratory
- 🔗 مشاهده پروفایل
آزمایشگاه پاتوبیولوژی مهر سینا
- آدرس: شیراز - 20 متری سينما سعدی، چهارراه معدل غربی
- نمایش لوکیشن روی نقشه
- شماره تماس: 07132335947 09177147729
- 🔗 مشاهده پروفایل
آزمایشگاه دکتر ابراهیمی
- آدرس: شیراز - خیابان اردیبهشت غربی، حدفاصل خیابان 20متری و فلسطین، نبش کوچه 5
- نمایش لوکیشن روی نقشه
- شماره تماس: 07132343860 09177274778
- 🔗 مشاهده پروفایل
در بالا، لیست آزمایشگاه های پاتوبیولوژی شیراز توسط وبسایت کارشد معرفی شده است. این مراکز خدمات تخصصی تشخیصی ارائه میدهند و اطلاعات هر آزمایشگاه به صورت شفاف ثبت شده است. کاربران میتوانند آدرس، اطلاعات تماس و موقعیت مکانی مراکز را بررسی کنند.
تجربه خود را در مورد این آزمایشگاه ها در بخش نظرات برای ما بنویسید.
آزمایشگاه پاتوبیولوژی در شیراز و بررسی خدمات
آزمایشگاه پاتوبیولوژی در شیراز خدمات تشخیصی متنوعی ارائه میدهد. این خدمات نقش کلیدی در تشخیص بسیاری از بیماری ها دارند. بررسی دقیق نمونه ها، پایه اصلی تصمیم گیری درمانی است.
خدمات رایج آزمایشگاه های پاتوبیولوژی شیراز عبارتند از:
- بررسی نمونه های بافتی و جراحی
- آزمایش های سیتولوژی و سلولی
- تشخیص تومورها و ضایعات خوش خیم و بدخیم
- ارائه گزارش تخصصی برای پزشکان
- تحلیل نتایج برای تعیین مسیر درمان
در آزمایشگاه های معتبر، نمونه برداری و پردازش طبق استاندارد انجام میشود. گزارش نهایی واضح، دقیق و قابل استناد است.
برای دریافت مشاوره و راهنمایی کلیک کنید.
بهترین آزمایشگاه پاتوبیولوژی در شیراز چه ویژگی هایی دارد؟
بهترین آزمایشگاه پاتوبیولوژی در شیراز آزمایشگاهی است که تشخیص دقیق، گزارش قابل اعتماد و تفسیر تخصصی ارائه دهد. استفاده از روش های استاندارد، حضور پزشک باتجربه و همکاری موثر با پزشکان معالج، مهمترین معیارهای انتخاب یک آزمایشگاه پاتوبیولوژی معتبر در شیراز هستند.
در مراکز معتبر پاتوبیولوژی، بررسی نمونه های بافتی و سلولی با دقت بالا انجام میشود. این دقت باعث کاهش خطای تشخیص و تصمیم گیری درمانی صحیح تر میشود. سرعت پاسخ دهی مناسب و شفافیت گزارش ها نیز نقش مهمی در اعتماد بیماران و پزشکان دارد.
ویژگی های بهترین آزمایشگاه پاتوبیولوژی شیراز
ویژگی های بهترین آزمایشگاه پاتوبیولوژی در شیراز شامل موارد زیر است:
- تشخیص دقیق بر اساس استانداردهای علمی
- حضور پزشک متخصص با تجربه
- استفاده از تجهیزات به روز و معتبر
- گزارش دهی شفاف و قابل استناد
- سرعت مناسب در پاسخ دهی نتایج
- اعتماد و رضایت پزشکان و بیماران
در نهایت، انتخاب بهترین آزمایشگاه پاتوبیولوژی شیراز تاثیر مستقیمی بر روند درمان دارد. بررسی تخصص، دقت و اعتبار آزمایشگاه کمک میکند مسیر درمان با اطمینان بیشتری طی شود. وبسایت کارشد، با جمع آوری اطلاعات مراکز معتبر، انتخاب را برای کاربران ساده تر و سریع تر کرده است.
جمع بندی و نکات پایانی
آزمایشگاه پاتوبیولوژی در شیراز نقش حیاتی در تشخیص دقیق بیماری ها دارد. بررسی تخصص، دقت تجهیزات و کیفیت گزارش دهی، معیارهای اصلی انتخاب هستند. کاربران با انتخاب درست میتوانند مسیر درمان را سریع تر و مطمئن تر طی کنند.
وبسایت کارشد؛ بانک مشاغل شیراز، در آذر 1404 لیست آزمایشگاه های پاتوبیولوژی شیراز را تهیه کرده است. این صفحه به شما کمک میکند بهترین انتخاب را با آگاهی کامل انجام دهید.
برای رزرو نوبت آنلاین یا تلفنی کلیک کنید.
برای آشنایی بیشتر با مفهوم پاتوبیولوژی و کاربردهای آن، میتوانید به مقاله ویکی پدیا مراجعه کنید.
سوالات متداول کاربران
در بیشتر موارد، مراجعه به آزمایشگاه پاتوبیولوژی در شیراز نیازمند نسخه پزشک است؛ زیرا نوع نمونه برداری و آزمایش باید توسط پزشک مشخص شود. نسخه باعث میشود بررسی نمونه دقیق تر انجام شود و گزارش نهایی برای تصمیم گیری درمانی قابل استناد باشد.
زمان آماده شدن جواب در آزمایشگاه های پاتوبیولوژی شیراز به نوع نمونه و پیچیدگی بررسی بستگی دارد. معمولا نتایج بین چند روز تا یک هفته آماده میشود. در موارد تخصصی تر، زمان پاسخ دهی ممکن است کمی بیشتر باشد.
آزمایشگاه پاتوبیولوژی بر بررسی نمونه های بافتی و سلولی تمرکز دارد و تشخیص های تخصصی ارائه میدهد. در مقابل، آزمایشگاه تشخیص طبی بیشتر آزمایش های عمومی خون و ادرار را انجام میدهد. پاتوبیولوژی نقش کلیدی در تشخیص نهایی بسیاری از بیماری ها دارد.
